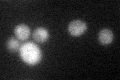

View description
Low-affinity inorganic phosphate (Pi) transporter, involved in activation of PHO pathway; expression is independent of Pi concentration and Pho4p activity; contains 12 membrane-spanning segments
Localization:
Intensity:
Fold change:
Significance:
-
C’ GFP library in SD

ER25.5 -
N' NOP1pr-GFP in SD

cell periphery65.4521 -
N' TEF2pr-mCherry in SD

missing0 -
N' NATIVEpr-GFP in SD

cell periphery,punctate21.246 -
N' TEF2pr-VC and Cyto-VN in SD

cell periphery,punctate31.4002 -
C’ GFP library in SD+DTT
ER19.230.75Yes -
C’ GFP library in SD+H2O2

ER20.10.78No -
C’ GFP library in Starvation Media

ER16.750.65Yes -
C’ GFP library on the background of Pup2-DaMP

N/A -
C’ GFP library on the background of CCT mutant

N/A0N/AYes
